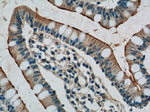
TLR1 Antibody in Immunohistochemistry (Paraffin) (IHC (P))

Search
Proteintech
TLR1 Polyclonal Antibody
{{$productOrderCtrl.translations['antibody.pdp.commerceCard.promotion.promotions']}}
{{$productOrderCtrl.translations['antibody.pdp.commerceCard.promotion.viewpromo']}}
{{$productOrderCtrl.translations['antibody.pdp.commerceCard.promotion.promocode']}}: {{promo.promoCode}} {{promo.promoTitle}} {{promo.promoDescription}}. {{$productOrderCtrl.translations['antibody.pdp.commerceCard.promotion.learnmore']}}
产品信息
19816-1-AP
种属反应
宿主/亚型
分类
类型
抗原
偶联物
形式
浓度
规格
纯化类型
保存液
内含物
保存条件
运输条件
产品详细信息
Immunogen sequence: LDLPWYLRM VCQWTQTRRR ARNIPLEELQ RNLQFHAFIS YSGHDSFWVK NELLPNLEKE GMQICLHERN FVPGKSIVEN IITCIEKSYK SIFVLSPNFV QSEWCHYELY FAHHNLFHEG SNSLILILLE PIPQYSIPSS YHKLKSLMAR RTYLEWPKEK SKRGLFWANL RAAINIKLTE QAKK (604-786 aa encoded by B C109093)
靶标信息
TLR1 protein is a member of the Toll-like receptor (TLR) family which plays a fundamental role in pathogen recognition and activation of innate immunity. TLRs are highly conserved from Drosophila to humans and share structural and functional similarities. They recognize pathogen-associated molecular patterns (PAMPs) that are expressed on infectious agents, and mediate the production of cytokines necessary for the development of effective immunity. The various TLRs exhibit different patterns of expression. The Toll-like receptor (TLR) family in mammals are comprised of a family of transmembrane proteins characterized by multiple copies of leucine rich repeats in the extracellular domain and an IL-1 receptor motif in the cytoplasmic domain. The TLRs could constitute an important and unrecognized component of innate immunity in humans. In mice, TLR1 interacts with TLR2 and co-expression of TLR1 and TLR2 enhance the NF-kappaB activation in response to a synthetic lipopeptide. They recognize the lipid configuration of the native mycobacterial lipoprotein as well as several tri-acylated lipopeptides. Different length transcripts presumably resulting from use of alternative polyadenylation site, and/or from alternative splicing, have been noted for the TLR1 gene.
仅用于科研。不用于诊断过程。未经明确授权不得转售。
生物信息学
蛋白别名: CD281; KIAA0012; TIL; TLR1; Toll-like receptor 1; Toll/interleukin-1 receptor-like protein; unnamed protein product
基因别名: CD281; KIAA0012; rsc786; TIL; TIL. LPRS5; TLR1
UniProt ID: (Human) Q15399, (Mouse) Q9EPQ1
Entrez Gene ID: (Human) 7096, (Mouse) 21897, (Rat) 305354